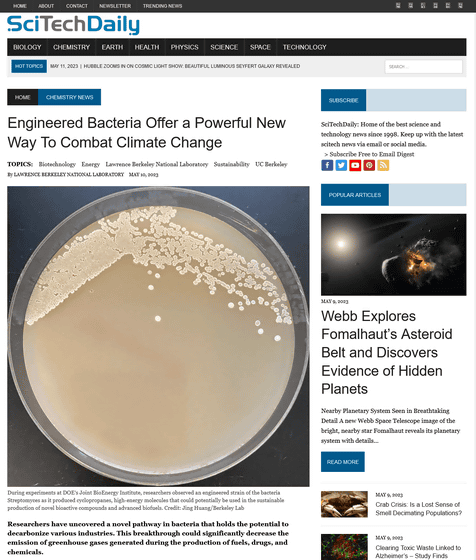

온실가스의 배출량을 대폭 감소시킬 수 있는, 인공 세균을 이용한 「카르벤 전이 반응」의 경로를 연구자들이 발견했습니다. 이 발견은 지속 가능한 바이오 화학 연료의 생산을 위한 전도 유망한 길을 열어 준다는 것입니다.
Complete integration of carbene-transfer chemistry into biosynthesis | Nature
https://doi.org/10.1038/s41586-023-06027-2
Engineered Bacteria Offer a Powerful New Way To Combat Climate Change
https://scitechdaily.com/engineered-bacteria-offer-a-powerful-new-way-to-combat-climate-change/
이것은 로렌스 버클리 국립 연구소와 캘리포니아 대학 버클리 학교의 공동 연구에 의해 발견되었습니다.
이전부터 연구자들은, 가전자(valence electron)를 6개밖에 가지지 않고, 전하를 가지지 않는, 2가의 탄소 화학종 「카르벤」을, 연료나 화학물질의 제조, 약품 개발이나 합성에 이용하고자 했습니다. 그러나, 카르벤 반응은 시험관을 사용하여 소량씩 밖에 실시할 수 없었고, 반응을 촉진하기 위해서는 고가의 화학물질이 필요했습니다. 이번 연구팀은 이 '비싼 화학물질'을 스트렙토미세스(Streptomyces)라는 박테리아의 유전자 변형 균주에서 생산 가능한 천연물로 대체했습니다.
이 인공 세균은 당을 사용하여 세포 대사에 의해 화학 물질을 생산합니다. 논문의 필자인 버클리 국립연구소 키슬링 랩 박사 연구원 Jing Huang 씨는 "이 연구에 의해 화학 합성에 일반적으로 사용되는 유독한 용매나 유독 가스를 사용하지 않고, 카르벤 반응을 실시할 수 있었습니다. 이 생물학적 과정은 오늘날 화학물질을 합성하는 방법보다 훨씬 친환경적입니다."라고 코멘트.
연구의 주임 연구자로 미 에너지성 바이오 에너지 연구소 CEO인 제이 키슬링 씨는 "당분을 더해 주기만 하면 되고, 나머지는 세포가 알아서 해 줍니다."라고 표현하고 있습니다.

연구에 사용된 인공 세균은 당을 대사 하여 카르벤 전구체와 알켄 기질로 변환하는 것 외에, 진화된 P450 효소를 발현하고, 카르벤 전구체와 알켄 기질을 이용하여 새로운 생물활성 화합물과 고도 바이오연료의 지속적인 생산에 사용할 수 있는 고에너지 분자인 사이클로프로판(cyclopropane)을 생성했습니다.
다만, Huang 씨에 의하면 상용화 준비는 아직 되어있지 않다고 합니다. Huang 씨는 "새로운 진보마다 누군가가 첫 발걸음을 내딛을 필요가 있습니다. 과학에서는 성공하기까지 몇 년이 걸릴 수 있습니다. 저는 우리의 일이 보다 친환경적이고 지속가능한 바이오제조 솔루션을 계속 찾도록 다른 사람들을 고무시킬 수 있기를 바랍니다."라고 말하고 있습니다.
'트렌드 이슈 · 토픽' 카테고리의 다른 글
| 심각한 장면에 코미디를 끼워 넣어 스토리에 설득력을 주는 「코믹 릴리프」기법이란? (5) | 2023.05.15 |
|---|---|
| 지중해 해저에서 "약 7000년 전에 만들어진 선사시대의 길" 발견 (3) | 2023.05.15 |
| 꽃 향기의 비누를 사용하면 모기에 잘 물리는 것이 판명, 모기에 물리지 않는 향은? (3) | 2023.05.15 |
| 찬 물에 들어가는 '냉수요법'은 오히려 건강에 악영향을 미친다 (4) | 2023.05.15 |
| 안드로이드의 「디바이스 찾기」기능이 확대되어 블루투스 트래커나 헤드폰에도 대응할 예정 (2) | 2023.05.12 |
| 구글이 실제 얼굴을 맞대고 대화하는 것 같은 '마법의 거울: Project Starline'을 개발중 (4) | 2023.05.12 |
| 「월면 착륙 미션이 얼마나 어려운지」를 Nature지 특파원이 말한다 (17) | 2023.05.09 |
| 고대 마야 문명의 「819일 주기 달력의 수수께끼」가 드디어 해명 (1) | 2023.05.09 |